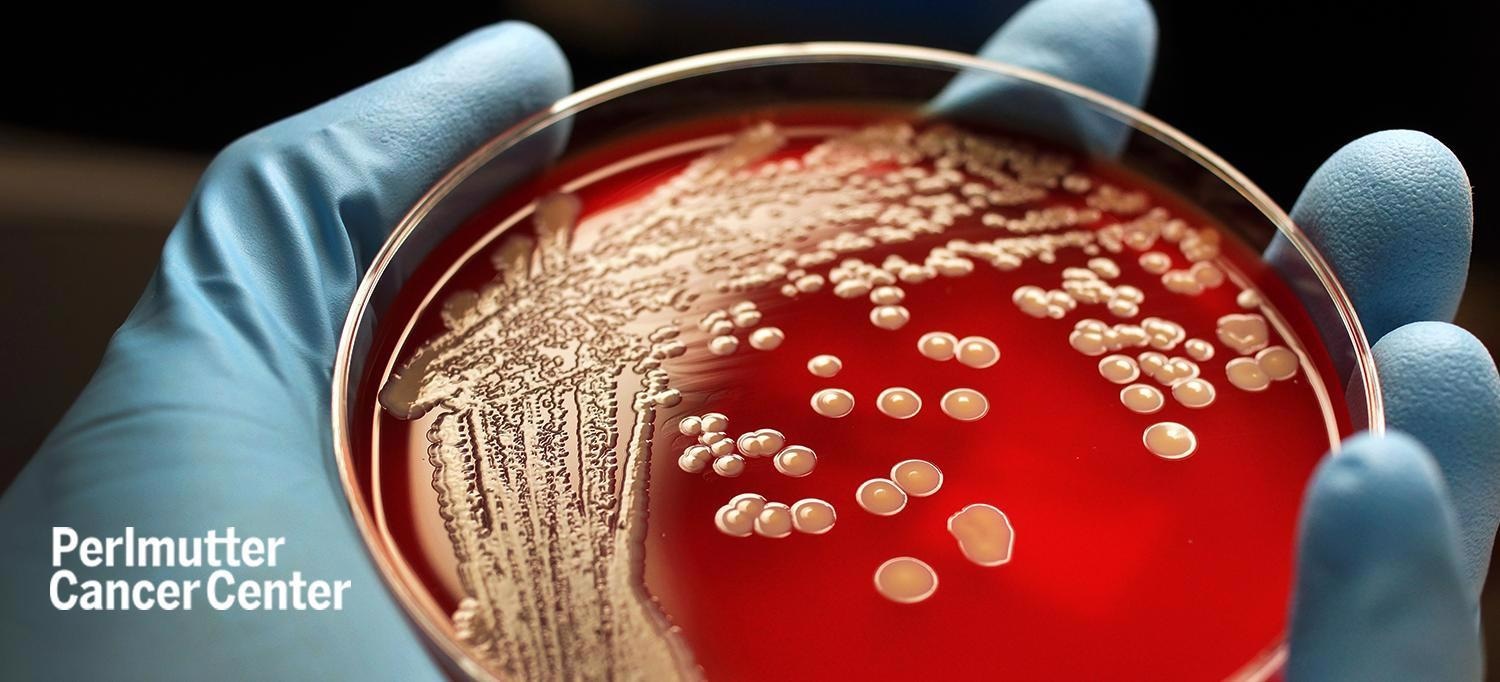

A study team developed an early-stage therapy that sabotages the pump and restores antibiotic efficiency by disclosing the structure of a protein needed by bacteria to pump out antibiotics.
Image Credit: Rodolfo Parulan Jr/Getty.
A new study conducted by researchers from NYU, NYU Grossman School of Medicine, and NYU Langone’s Laura and Isaac Perlmutter Cancer Center used advanced microscopy to “see” for the first time the structure of NorA, a protein that Staphylococcus aureus utilizes to pump out widely used antibiotics before they can destroy them.
Efflux pumps are one method through which S. aureus has developed resistance to fluoroquinolone, a group that encloses more than 60 approved antibiotics, which include norfloxacin (Noroxin), levofloxacin (Levaquin), and ciprofloxacin (Cipro).
According to the researchers, fluoroquinolones are no longer effective against some drug-resistant bacterial strains, such as methicillin-resistant S. aureus (MRSA), which is a leading cause of mortality among hospitalized patients when the infection becomes severe. As a result, researchers have been working on developing efflux pump inhibitors (EPIs), although early attempts have been restricted by adverse effects.
Instead of trying to find a new antibiotic, we hope to make the most widely used antibiotics over the last few decades, rendered ineffective by bacterial resistance, highly effective again.”
Doug Brawley, PhD, Study First Author, Skirball Institute of Biomolecular Medicine, New York University Grossman School of Medicine
Nathaniel J. Traaseth, PhD, a professor in the Department of Chemistry at NYU, and Da-Neng Wang, PhD, a professor in the Department of Cell Biology at NYU Grossman School of Medicine, were senior authors of Brawley’s doctorate thesis.
Antibodies to the Rescue
The work, which was published online on March 31st in the journal Nature Chemical Biology, relies on recent developments in antibody technology development. Invading bacteria cause the immune system to produce a variety of antibodies, which are proteins that are designed to adhere to and neutralize certain invaders.
Antibodies were utilized in the current investigation to overcome a difficulty that had prevented the structure of NorA from being studied. Dr Brawley spent years developing the expression and purification conditions for this study, yet the NorA molecule is so small that even modern cryo-electron microscopy (cryo-EM) cannot identify it.
As a result, the researchers tested a wide array of synthetic antibodies gathered by the senior author of the study Shohei Koide, PhD, professor in the Department of Biochemistry and Molecular Pharmacology at NYU Grossman School of Medicine, to discover the ones that connected to NorA the most firmly.
The scientists virtually doubled the size of NorA by adding antibodies to it, which improved cryo-EM pictures and exposed the NorA pump’s structure for the first time.
The research also showed the area where the team’s lead antibody docked onto NorA, much like a key does in a lock. The researchers were shocked to discover that the location where this antibody was inserted into NorA was the same one where NorA grabs onto antibiotics and eliminates them. These findings showed that the antibody may inhibit bacterial growth by blocking the pump and allowing antibiotics to stay within bacterial cells.
The scientists also discovered that the region of the antibody most firmly embedded in NorA’s binding cavity was a short, looping peptide, a section of protein building blocks, according to the cryo-EM structure. “We became excited that an isolated peptide corresponding to the loop by itself might inhibit NorA,” adds Dr Traaseth.
When paired with the antibiotic norfloxacin, the scientists discovered that this peptide (dubbed NPI-1) functioned as an EPI and inhibited antibiotic-resistant S. aureus multiplication in dishes with nutrients (cultures) by more than 95% at high doses.
In the structural pocket where NorA connects to antibiotic molecules, the EPI had several interactions with protein-building components, according to the structural study.
This makes it highly unlikely that bacteria could develop resistance to such a treatment because they would have to randomly evolve to somehow defeat the EPI without taking away the ability of the efflux pump site to grab antibiotics.”
Da-Neng Wang, PhD, Professor, Department of Cell Biology, New York University Grossman School of Medicine
The team is trying to enhance the design of its EPI in the future. According to the authors, each NPI-1 residue may be adjusted for better efficacy and to decrease any potential negative effects. Their approach to creating synthetic antibodies against NorA-like efflux pumps should aid in the discovery of EPIs for other diseases that rely on pumps, such as Streptococcus pneumonia and Mycobacterium tuberculosis.
The discovery of this new way to inhibit MRSA demonstrates that five labs from four departments—with complementary expertise in structural biology, protein engineering, peptide chemistry, and microbiology—can collaborate to accomplish what none could alone.”
Dr Shohei Koide, PhD, Professor, Department of Biochemistry and Molecular Pharmacology New York University Grossman School of Medicine
Source:
Journal reference:
Brawley, D. N., et al. (2022) Structural basis for inhibition of the drug efflux pump NorA from Staphylococcus aureus. Nature Chemical Biology. doi.org/10.1038/s41589-022-00994-9.